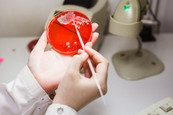
Эксплана на Павлова, фото №3

Лаборатория Эксплана (Explana) на Павлова (Клиника закрыта)

6 фото
Зарегистрируйтесь
Описание клиники
Эксплана на Павлова - филиал сети частных лабораторий с ближайшим метро - Петроградская. В лаборатории принимают взрослых и детей.
Современная техническая оснащённость лаборатории позволяет проводить практически любые анализы, например: тест на коронавирус, различные цитологические исследования и пробы, гастропанель, анализы на гормоны, витамины, аллергопробы, на TORCH-инфекции, квантифероновый тест на туберкулез, T-Spot, HLA-типирование, анализы на наркотики и многое другое.
Преимущества
Узкопрофильная клиника
Отзывы
(9)Сортировать:
- сначала с текстом
- по дате

Услуга: Анализ на витамин Д

Услуга: ПЦР-тест на коронавирус
Прекрасное отношение

Анализ на витамин Д
Лицензии и сертификаты








